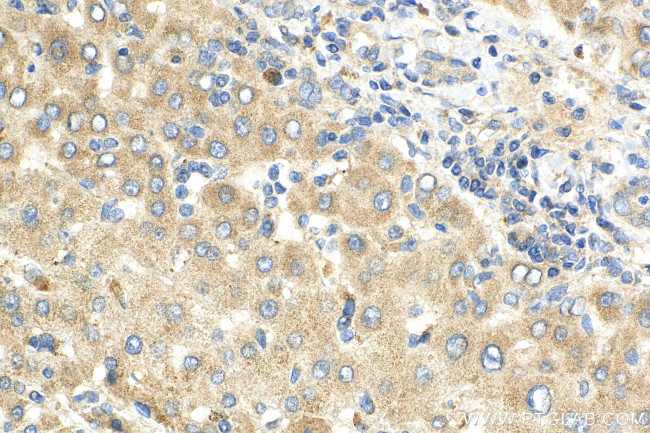
Complement factor H Antibody in Immunohistochemistry (Paraffin) (IHC (P))

Search
Proteintech
Complement factor H Polyclonal Antibody
{{$productOrderCtrl.translations['antibody.pdp.commerceCard.promotion.promotions']}}
{{$productOrderCtrl.translations['antibody.pdp.commerceCard.promotion.viewpromo']}}
{{$productOrderCtrl.translations['antibody.pdp.commerceCard.promotion.promocode']}}: {{promo.promoCode}} {{promo.promoTitle}} {{promo.promoDescription}}. {{$productOrderCtrl.translations['antibody.pdp.commerceCard.promotion.learnmore']}}
图: 1 / 6
Complement factor H Antibody (12748-1-AP) in IHC (P)






产品信息
12748-1-AP
种属反应
宿主/亚型
分类
类型
抗原
偶联物
形式
浓度
规格
纯化类型
保存液
内含物
保存条件
运输条件
产品详细信息
Immunogen sequence: LPPRRNTEI LTGSWSDQTY PEGTQAIYKC RPGYRSLGNV IMVCRKGEWV ALNPLRKCQK RPCGHPGDTP FGTFTLTGGN VFEYGVKAVY TCNEGYQLLG EINYRECDTD GWTNDIPICE VVKCLPVTAP ENGKIVSSAM EPDREYHFGQ AVRFVCNSGY KIEGDEEMHC SDDGFWSKEK PKCVEISCKS PDVINGSPIS QKIIYKENER FQYKCNMGYE YSERGDAVCT ESGWRPLPSC EEKSCDNPYI PNGDYSPLRI KHRTGDEITY QCRNGFYPAT RGNTAKCTST GWIPAPRCTL KPCDYPDIKH GGLYHENMRR PYFP (24-346 aa encoded by BC037285)
靶标信息
Factor H is a serum protein acting as an inhibitor in the complement activation system. I activates the C3/C5 convertase by dissociating its subunits and also acts as a cofactor for the enzyme activity of Factor I.
仅用于科研。不用于诊断过程。未经明确授权不得转售。
生物信息学
蛋白别名: adrenomedullin binding protein; age-related maculopathy susceptibility 1; beta-1-H-globulin; beta-1H; Complement factor H; complement H factor; complement protein H; factor H; factor H-like 1; FHL1 antibody; H factor 1; H factor 1 (complement); H factor 2 (complement); HGNC:4883; MGC88246; RP1-177P10.1; unnamed protein product
基因别名: AHUS1; AMBP1; ARMD4; ARMS1; CFH; CFHL3; FH; FHL1; HF; HF1; HF2; HUS
UniProt ID: (Human) P08603
Entrez Gene ID: (Human) 3075